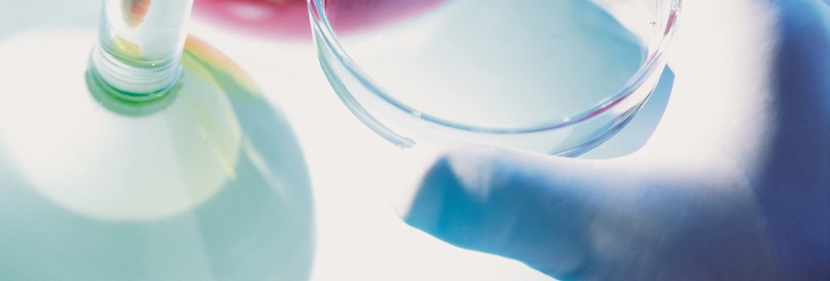
洗滌消毒劑備案檢測

臭氧消毒器備案檢測
健明迪檢測提供的臭氧消毒器備案檢測,檢測項目 殺菌因子強度(臭氧濃度,具有CMA,CNAS資質。

臭氧消毒器備案 檢測項目
殺菌因子強度(臭氧濃度,含變化曲線)、臭氧泄漏量、臭氧殘留量、紫外線泄漏量、空氣消毒實驗室試驗、空氣消毒現場試驗、大腸桿菌定量殺菌試驗(含中和劑鑒定)、金黃色葡萄球菌定量殺菌試驗、鉛砷、模擬現場(或現場試驗)、總體性能試驗、等等
臭氧消毒器 備案要求
國家衛健委要求第一類、第二類消毒產品首次上市前需要自行或委托第三方進行衛生安全評價,評價合格的消毒產品形成《消毒產品衛生安全評價報告》進行網上備案、銷售。省級衛生計生行政部門對衛生安全評價報告進行形式審查,資料齊全的應當在5個工作日內向產品責任單位出具備案憑證,并對備案的衛生安全評價報告加蓋騎縫章。健明迪檢測開展臭氧消毒器備案檢測服務,具備CMA、CNAS資質認證。
臭氧消毒器備案檢測 評價內容
衛生安全評價內容包括產品標簽(銘牌)、說明書,檢驗報告(含結論)、企業標準或質量標準,國產產品生產企業衛生許可資質,進口產品生產國(地區)允許生產銷售的批文情況。其中、消毒劑、生物指示物,化學指示物,帶有標識的滅菌物品包裝物、抗(抑)菌制劑還包括產品配方,消毒器械還應當包括產品主要元器件、結構圖。
責任單位的衛生安全評價應當形成完整的《消毒產品衛生安全評價報告》。評價報告包括基本情況和評價資料兩部分。